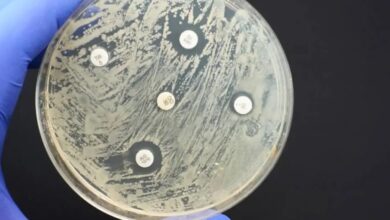

pandemia
-
Salud

La “pandemia silenciosa” que mata más personas que el Covid-19, la malaria y el sida
Más de 1,2 millones de personas murieron en todo el mundo en 2019 como consecuencia directa de infecciones causadas por…
Leer más » -
Internacionales

En la selva maya, científicos rastrean virus que podrían desatar nuevas pandemias
Anochece en la selva mexicana de Yucatán, donde el veterinario Omar García extrae sangre y fluidos a un murciélago que…
Leer más » -
Internacionales

OMS advirtió que la gripe aviar podría causar una pandemia
La Organización Mundial de la Salud advirtió que la humanidad debe prepararse para una posible pandemia de gripe aviar humana. Porque hay riesgo de que…
Leer más » -
Nacionales

OMS decidirá este viernes si se levanta la pandemia
La Organización Mundial de la Salud realizará el próximo 27 de enero un encuentro en la ciudad de Ginebra, Suiza,…
Leer más » -
Internacionales

Hospitales desbordados en China tras ola de casos por Covid
En un hospital desbordado por la ola de covid, una enfermera entrega un certificado de defunción. Tres años después de…
Leer más » -
Salud

Investigadores aseguran que el estrés de la pandemia envejeció el cerebro de los adolescentes
El estrés que ha supuesto la pandemia de Covid-19 envejeció físicamente, como si hubieran envejecido varios años, los cerebros de…
Leer más » -
Salud

Tripledemia: cómo impacta el aumento simultáneo del Covid-19, la gripe y la bronquiolitis
La suba de casos afecta a EEUU, España y el resto de Europa. La amenaza de las tres infecciones ya…
Leer más » -
Internacionales

La «Tomatina» de España regresa tras pausa por la pandemia
Trabajadores en camiones descargaron 130 toneladas de tomates pasados de maduros en la calle principal de Buñol para que los…
Leer más » -
COVID-19

En las últimas 24 horas se registraron 326 nuevos casos de Covid-19 en Venezuela
Rodríguez detalló que lamentablemente, en las últimas horas, dos venezolanos fallecieron a causa del virus Delcy Rodríguez, informó la noche…
Leer más » -
Internacionales

Alertan nueva ola de Covid-19 en Europa
La OMS recuerda que se debería promover el uso de mascarillas en interiores y en el transporte público, ventilar los…
Leer más »